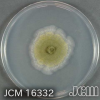

-
Welcome to the discussion forums. To get posting, register an account.
You are using an out of date browser. It may not display this or other websites correctly.
You should upgrade or use an alternative browser.
You should upgrade or use an alternative browser.
Game Counting in Pictures
- Thread starter Lucas
- Start date